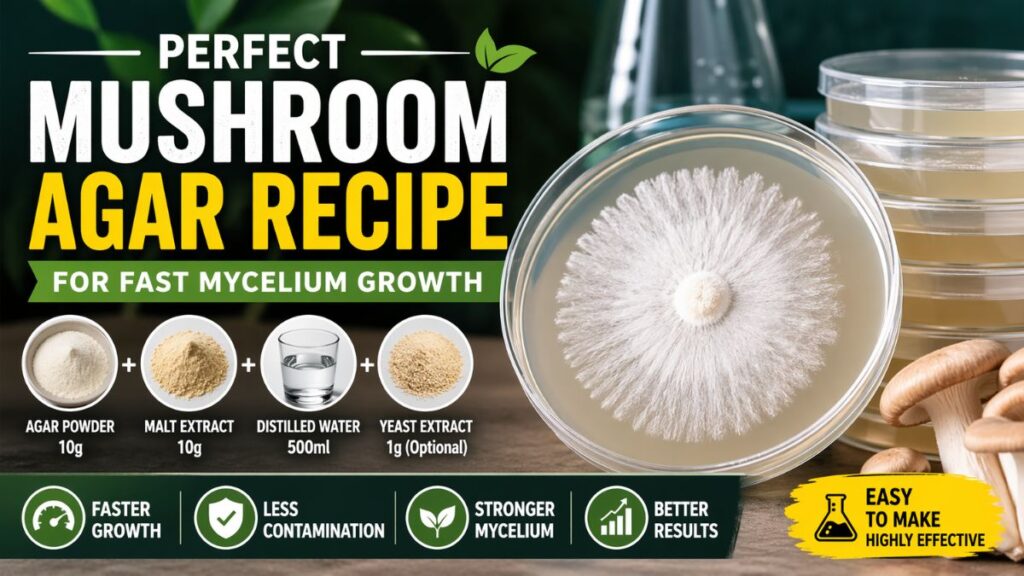
Perfect Mushroom Agar Recipe

If your mushroom cultures are growing slowly—or worse, getting contaminated—the problem often starts with your agar. A Perfect Mushroom Agar Recipe isn’t just a mix of ingredients; it’s the foundation of fast, healthy mycelium growth. Whether you’re a beginner or scaling up your cultivation, mastering agar can dramatically improve your success rate, save time, and boost yields. Ready to unlock cleaner cultures and faster colonization? Let’s dive in.
What Makes a Perfect Mushroom Agar Recipe?
Understanding the Role of Agar in Mycology
Agar is a nutrient-rich medium that supports mycelium growth in a controlled environment. It allows cultivators to:
- Isolate strong genetics
- Detect contamination early
- Speed up colonization
A well-balanced agar recipe provides carbohydrates, nutrients, and the right texture for optimal growth.
Essential Ingredients for Fast Mycelium Growth
To create the Perfect Mushroom Agar Recipe, you’ll need:
- Agar powder (10g) – Solidifying agent
- Light malt extract (10g) – Primary nutrient source
- Distilled water (500ml) – Clean base
- Optional: Yeast extract (1g) for extra nutrients
This combination is often referred to as a best agar recipe for mushroom cultivation due to its simplicity and effectiveness.
Step-by-Step Mushroom Agar Preparation Guide
Simple Process for Beginners
Follow this step-by-step mushroom agar preparation to get consistent results:
- Mix Ingredients
Combine agar powder, malt extract, and water in a heat-safe container. - Heat and Dissolve
Gently heat while stirring until everything dissolves completely. - Sterilize the Mixture
- Pour into a flask or bottle
- Pressure cook at 15 PSI for 20–25 minutes
- Cool Slightly
Let the mixture cool to around 45–50°C before pouring. - Pour into Petri Dishes
Work in a clean environment (preferably a still air box or laminar flow hood). - Let It Solidify
Agar sets within 10–20 minutes.
Safety Precautions You Should Never Ignore
- Always sterilize tools and workspace
- Wear gloves and a mask to prevent contamination
- Avoid pouring agar when it’s too hot (reduces condensation)
Tips for Faster Mycelium Growth on Agar
To improve results with your fast mycelium growth agar recipe, follow these expert tips:
- Use fresh ingredients for better nutrient quality
- Maintain consistent temperatures (20–25°C)
- Store plates upside down to prevent moisture buildup
- Label and date all cultures
Common Mistakes and Pro Tips for Success
Mistakes That Slow Down Growth
Even with a solid homemade mushroom agar recipe, these errors can ruin your results:
- Overcooking agar – Destroys nutrients
- Poor sterilization – Leads to contamination
- Too much moisture – Encourages bacteria
- Incorrect nutrient ratio – Weak or slow growth
Pro-Level Best Practices
Want to level up your agar game? Try these:
- Experiment with additives like activated charcoal
- Use parafilm or micropore tape for sealing plates
- Practice agar transfers to isolate strong strains
- Keep a cultivation journal for tracking progress
Why This Recipe Works So Well
The balance of malt extract and agar creates a stable, nutrient-rich medium that supports aggressive mycelium expansion. This is why it’s widely considered the Perfect Mushroom Agar Recipe for both beginners and professionals.
FAQs:
1. How long does agar last after preparation?
Properly stored agar plates can last 2–4 weeks in a refrigerator.
2. Can I make agar without a pressure cooker?
Yes, but it increases contamination risk. A pressure cooker is highly recommended.
3. What temperature is best for agar colonization?
Most species thrive between 20–25°C for optimal growth.
Conclusion:
Mastering the Perfect Mushroom Agar Recipe is a game-changer for anyone serious about mushroom cultivation. It gives you control, consistency, and cleaner results—leading to faster mycelium growth and higher success rates. Start small, follow the steps, and refine your technique with practice.
Ready to simplify your process? Try this handy tool to get precise measurements every time:
👉 https://mushroomcalculators.com/tool/mushroom-agar-recipe-calculator/



